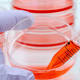

greenMe.it | Stop ai test sugli animali: quelli sulle colture cellulari sono ugualmente efficaci greenMe.it Possiamo dirlo? Finalmente! Oggi è un giorno importante, tutte le maggiori agenzie di stampa e quotidiani riportano questa notizia: i test sugli animali possono (e aggiungiamo noi devono) essere sostituiti da quelli sulle colture cellulari dato che ... Test sugli animali sostituiti da quelli sulle celluleANSA.it Sperimentazione sugli animali non più necessaria: rivoluzione nel mondo della ricercaBlasting News Se i test non ci sono i topi ballano: addio sperimentazioni sugli animali?Intelligonews News24web -Julie News -Consumatrici tutte le notizie (17) » |
